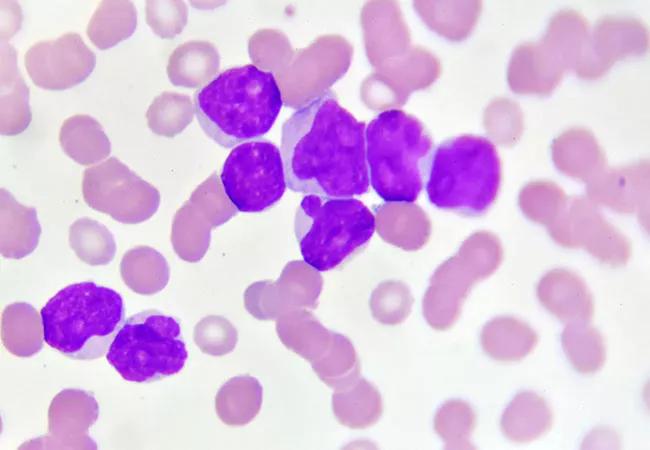

Prior history of autoimmunity and solid organ transplantation significantly increases chance of myelodysplastic syndrome or acute myeloid leukemia
Image content: This image is available to view online.
View image online (https://assets.clevelandclinic.org/transform/dcd12a76-2c38-42b9-82b4-75f0bba00b1e/22-CNR-3405918-CQD-Hero-650x450-breast-cancer_jpg)
breast cancer cells
A large, population-based study sheds light on which breast cancer survivors over the age of 65 year are at an increased risk for subsequent myelodysplastic syndrome (MDS) or acute myeloid leukemia (AML). This data, which was presented during the 64th annual meeting of the American Society of Hematology (ASH), provides valuable insights to clinicians caring for these patients and uncovers several areas that warrant further study.
Advertisement
Cleveland Clinic is a non-profit academic medical center. Advertising on our site helps support our mission. We do not endorse non-Cleveland Clinic products or services. Policy
“As survival rates improve, we have a growing cohort of long-term cancer survivors,” notes study author Abhay Singh, MD, MPH, a physician with the Department of Hematology and Medical Oncology at Cleveland Clinic. “Many of these individuals have been exposed to chemoradiotherapy and they are at risk of developing therapy-related myeloid neoplasms, which includes therapy-related myelodysplastic syndrome (tMDS) and acute myeloid leukemia (tAML).”
Therapy-related myeloid neoplasms (tMNs) have a very poor prognosis, according to Dr. Singh, who notes that median survival is approximately six to eight months. “Only a small percentage of patients who undergo chemoradiotherapy will develop tMNs,” he says. “A large majority of patients who are exposed to these therapies do not have this outcome, which suggests that there are other factors at play that might facilitate tMNs.”
Recognizing this, Dr. Singh and colleagues sought to find out what else may contribute to the development of these conditions beyond chemoradiotherapy. Specifically, they wanted to better understand if clonal hematopoiesis-associated comorbidities play a role in clonal hematopoiesis’s evolution to tMN.
Dr. Singh and colleagues conducted a population-based retrospective cohort study using cancer registries from the SEER Program and Medicare claims database. Their analyses included female patients ages 66 to 84 years who were diagnosed with their first primary breast cancer between 2000 to 2014 with follow-up through 2015 and who survived at least one year.
Advertisement
The study authors used the claims database to classify individuals with a medical comorbidity of interest if they had at least one hospital claim, or two physician/outpatient claims at least 30 days apart for that comorbidity.
Among the 233,206 female breast cancer patients included in this analysis, the researchers identified 711 tMDS/AML cases with a median age of 73 years. As previous studies have reported, the data showed that tMDS/AML occurred more often after initial chemotherapy and radiation.
Patients who had undergone a prior solid organ transplantation were three times more likely to develop tMDS/AML. Additionally, patients with a prior history of autoimmune conditions had a significantly higher risk of subsequent tMDS/AML. Use of growth factor was also identified as a risk factor for subsequent malignancy.
The study authors reported that no other comorbidities, including high blood pressure, dyslipidemia and diabetes, were associated with an increased risk of subsequent tMDS/AML among the study population.
It has been well established that there is an excess risk of tMDS/AML following chemoradiotherapy, and the data from this study further supports this conclusion. Novel findings from this research also suggest that other mediators/selection pressures are involved in malignant evolution of clonal hematopoiesis after chemoradiotherapy exposure to facilitate development of tMNs.
“Our research show us that there is more than meets the eye,” says Dr. Singh. “These results are not intended to paint these treatments in a negative light. They are very valuable to many patient populations, but this work does underscore the need for further study to better care for patients who may be at greater risk for subsequent malignancies.”
Advertisement
Based on these findings, Dr. Singh and colleagues suggest that common clinical practices, such as the use of G-CSF in solid tumor malignancies as the primary way to limit neutropenia, should be reconsidered and modified.
“Future studies should evaluate these findings longitudinally at a molecular level in high-risk patients to enhance clinical decision making,” concludes Dr. Singh. “Further clarification of these selective pressures as well as incorporation of clinical risk prediction models to guide treatment could help us mitigate the risk of tMDS/AML.”
Learn more in our podcast episode about identifying risk factors for secondary malignancy in breast cancer survivors.
Advertisement
Advertisement
First-of-its-kind research investigates the viability of standard screening to reduce the burden of late-stage cancer diagnoses
Global R&D efforts expanding first-line and relapse therapy options for patients
Study demonstrates ability to reduce patients’ reliance on phlebotomies to stabilize hematocrit levels
A case study on the value of access to novel therapies through clinical trials
Findings highlight an association between obesity and an increased incidence of moderate-severe disease
Cleveland Clinic Cancer Institute takes multi-faceted approach to increasing clinical trial access 23456
Key learnings from DESTINY trials
Overall survival in patients treated since 2008 is nearly 20% higher than in earlier patients